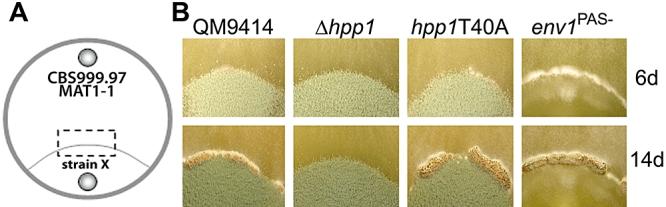

在子囊菌中存在一类新型的肽信息素前体。
A novel class of peptide pheromone precursors in ascomycetous fungi.
机构信息
Research Area Gene Technology and Applied Biochemistry, Institute of Chemical Engineering, Vienna University of Technology, Getreidemarkt 9/1665, Vienna 1060, Austria.
出版信息
Mol Microbiol. 2010 Sep;77(6):1483-501. doi: 10.1111/j.1365-2958.2010.07295.x.
Recently, sexual development in the heterothallic ascomycete Trichoderma reesei (anamorph of Hypocrea jecorina) has been achieved and thus initiated attempts to elucidate regulation and determinants of this process. While the α-type pheromone of this fungus fits the consensus known from other fungi, the assumed a-type peptide pheromone precursor shows remarkably unusual characteristics: it comprises three copies of the motif (LI)GC(TS)VM thus constituting a CAAX domain at the C-terminus and two Kex2-protease sites. This structure shares characteristics of both a- and α-type peptide pheromone precursors. Presence of hybrid-type peptide pheromone precursor 1 (hpp1) is essential for male fertility, thus indicating its functionality as a peptide pheromone precursor, while its phosphorylation site is not relevant for this process. However, sexual development in a female fertile background is not perturbed in the absence of hpp1, which rules out a higher order function in this process. Open reading frames encoding proteins with similar characteristics to HPP1 were also found in Fusarium spp., of which Fusarium solani still retains a putative a-factor-like protein, but so far in no other fungal genome available. We therefore propose the novel class of h-type (hybrid) peptide pheromone precursors with H. jecorina HPP1 as the first member of this class.
最近,异宗配合的曲霉菌(Hypocrea jecorina 的同物异名)的性发育已经实现,因此人们开始尝试阐明这个过程的调控机制和决定因素。虽然该真菌的α-型信息素符合其他真菌已知的共识,但假定的α-型肽信息素前体表现出非常不寻常的特征:它由三个(LI)GC(TS)VM 基序组成,因此在 C 末端构成一个 CAAX 结构域和两个 Kex2 蛋白酶位点。这种结构具有α-和 α-型肽信息素前体的特征。杂种型肽信息素前体 1(hpp1)的存在对于雄性育性是必不可少的,因此表明其作为肽信息素前体的功能,而其磷酸化位点与该过程无关。然而,在不存在 hpp1 的情况下,具有雌性育性的背景中的性发育不会受到干扰,这排除了该过程中的更高阶功能。在 Fusarium spp. 中也发现了具有类似特征的编码蛋白的开放阅读框,其中 Fusarium solani 仍然保留了一个假定的 a 因子样蛋白,但迄今为止在其他真菌基因组中尚未发现。因此,我们提出了新型的 h 型(杂种)肽信息素前体,以 Hypocrea jecorina HPP1 作为该类别的第一个成员。